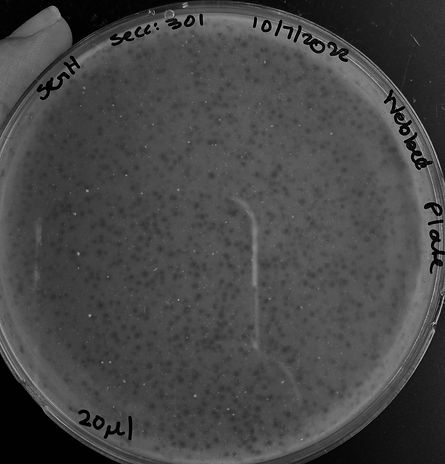
Phage Morphology

About Me.
I'm from Aguas Buenas, and I'm currently pursuing a Master's in Preventive Veterinary Medicine with the goal of becoming a Doctor in Veterinary Medicine.
I've had the opportunity to participate in various sterilization activities, clinics, adoption events, and even vaccination fairs, through this, I've seen that this profession is beautiful, much like the special people in this field.
My motivation for joining this profession is to help raise awareness, educate the island, promote adoption, and contribute to reducing the overpopulation of stray animals on the island. I'm super excited and happy to be part of this community.
Fun facts: I love mushrooms, the beach, socks with random designs, and I've gone skydiving three times.
Education
2025-Present
Master's In Preventive Veterinary Medicine in University of California, Davis
To further strengthen my academic background, gain more experience, and improve my GPA, I will be starting a Master’s program in Preventive Veterinary Medicine. This program will allow me to deepen my understanding of public health, epidemiology, and animal disease prevention, while also preparing me for the next step in my journey—applying to veterinary school.
2019-2025
Bachelor's in Science and Technology with a concentration in Biology in Ana G. Méndez University, Gurabo
My bachelor's degree journey began during the Covid-19 pandemic, with online classes. Despite this, I joined various organizations both within and outside the university, obtaining certifications and taking workshops ranging from microbiology to veterinary studies.
2015-2018
General Studies in Urban Vocacional High School, Aguas Buenas
During my studies at the vocational high school, I participated in the school band in my first year The flute was my instrument. I played at the graduation ceremony for the Class of 2016 and at the graduation of a middle school in Caguas. Additionally, in the Theater class, we performed a play for the final project, which was presented to different classes. I graduated with high honors, and in 12th grade, I was invited by the Capitol in San Juan to an event called 'Tutor by Excellence,' where they recognize the parents of students who were part of the honor roll for all three years of high school.
Organizations
I am a dedicated member of various organizations that have played a pivotal role in my professional growth within the fields of science and veterinary medicine. These associations have been invaluable sources of learning, developmental opportunities, and meaningful connections with prominent professionals in my field. Through my active involvement in these groups, I have stayed abreast of the latest advances in veterinary research and practice while contributing to the exchange of knowledge and experiences with passionate colleagues. These experiences have enriched me both personally and professionally, forging a strong network and providing me with a comprehensive perspective that enhances my journey in the sciences and veterinary medicine.
1
Microbiologists Society of Puerto Rico
2
Social Movement Pro Animal Welfare
3
Veterinarians For Puerto Rico

4
S.O.S. Vet
5
El Foster Club
6
Luna Vet Help
Experiences
Within these pictures, I invite you to delve into my immersive journey in the field of veterinary medicine, offering you a firsthand glimpse into the tapestry of my experiences. Uncover the pivotal moments that have defined and enriched my professional trajectory, each representing a meaningful chapter in my dedication to the world of veterinary care.